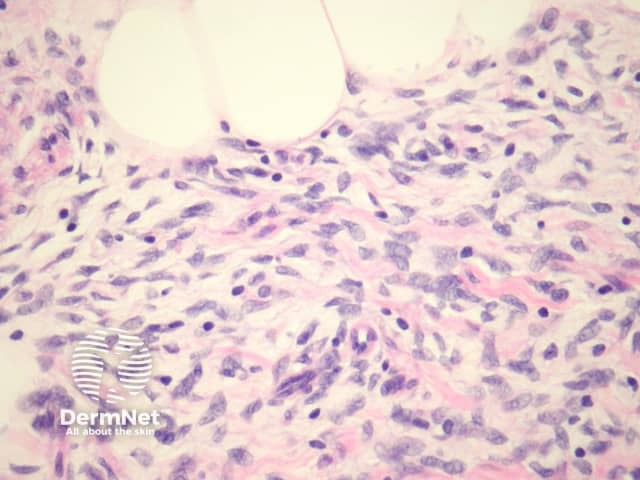
Figure 2

Main menu
Common skin conditions
NEWS
Join DermNet PRO
Read more
Quick links
Lesions (benign) Diagnosis and testing
Author: Assoc Prof Patrick Emanuel, Dermatopathologist, Auckland, New Zealand, 2013.
Fibrous hamartoma of infancy is a benign mesenchymal tumour of myofibroblastic derivation with prototypical histopathologic features. Tumours usually present as solitary masses on the limbs, trunk, sacrum, or scrotum
In fibrous hamartoma of infancy, bundles of well-defined thick connective tissue, which branch, interweave, and project into adjacent fat (figure 1). The lesion is composed of three components: adipose tissue, myofibroblasts (best seen in figure 2), and primitive mesenchymal cells (best seen in figure 3). The distinctive primitive mesenchymal tissue organized in distinct whorls, bands, or nests (figure 3). Myxoid change may be prominent.

Figure 1
Figure 2

Figure 3
The myofibroblasts stain with actin and calponin. S100 is negative.
Neurofibroma – S100 is positive in neurofibroma.